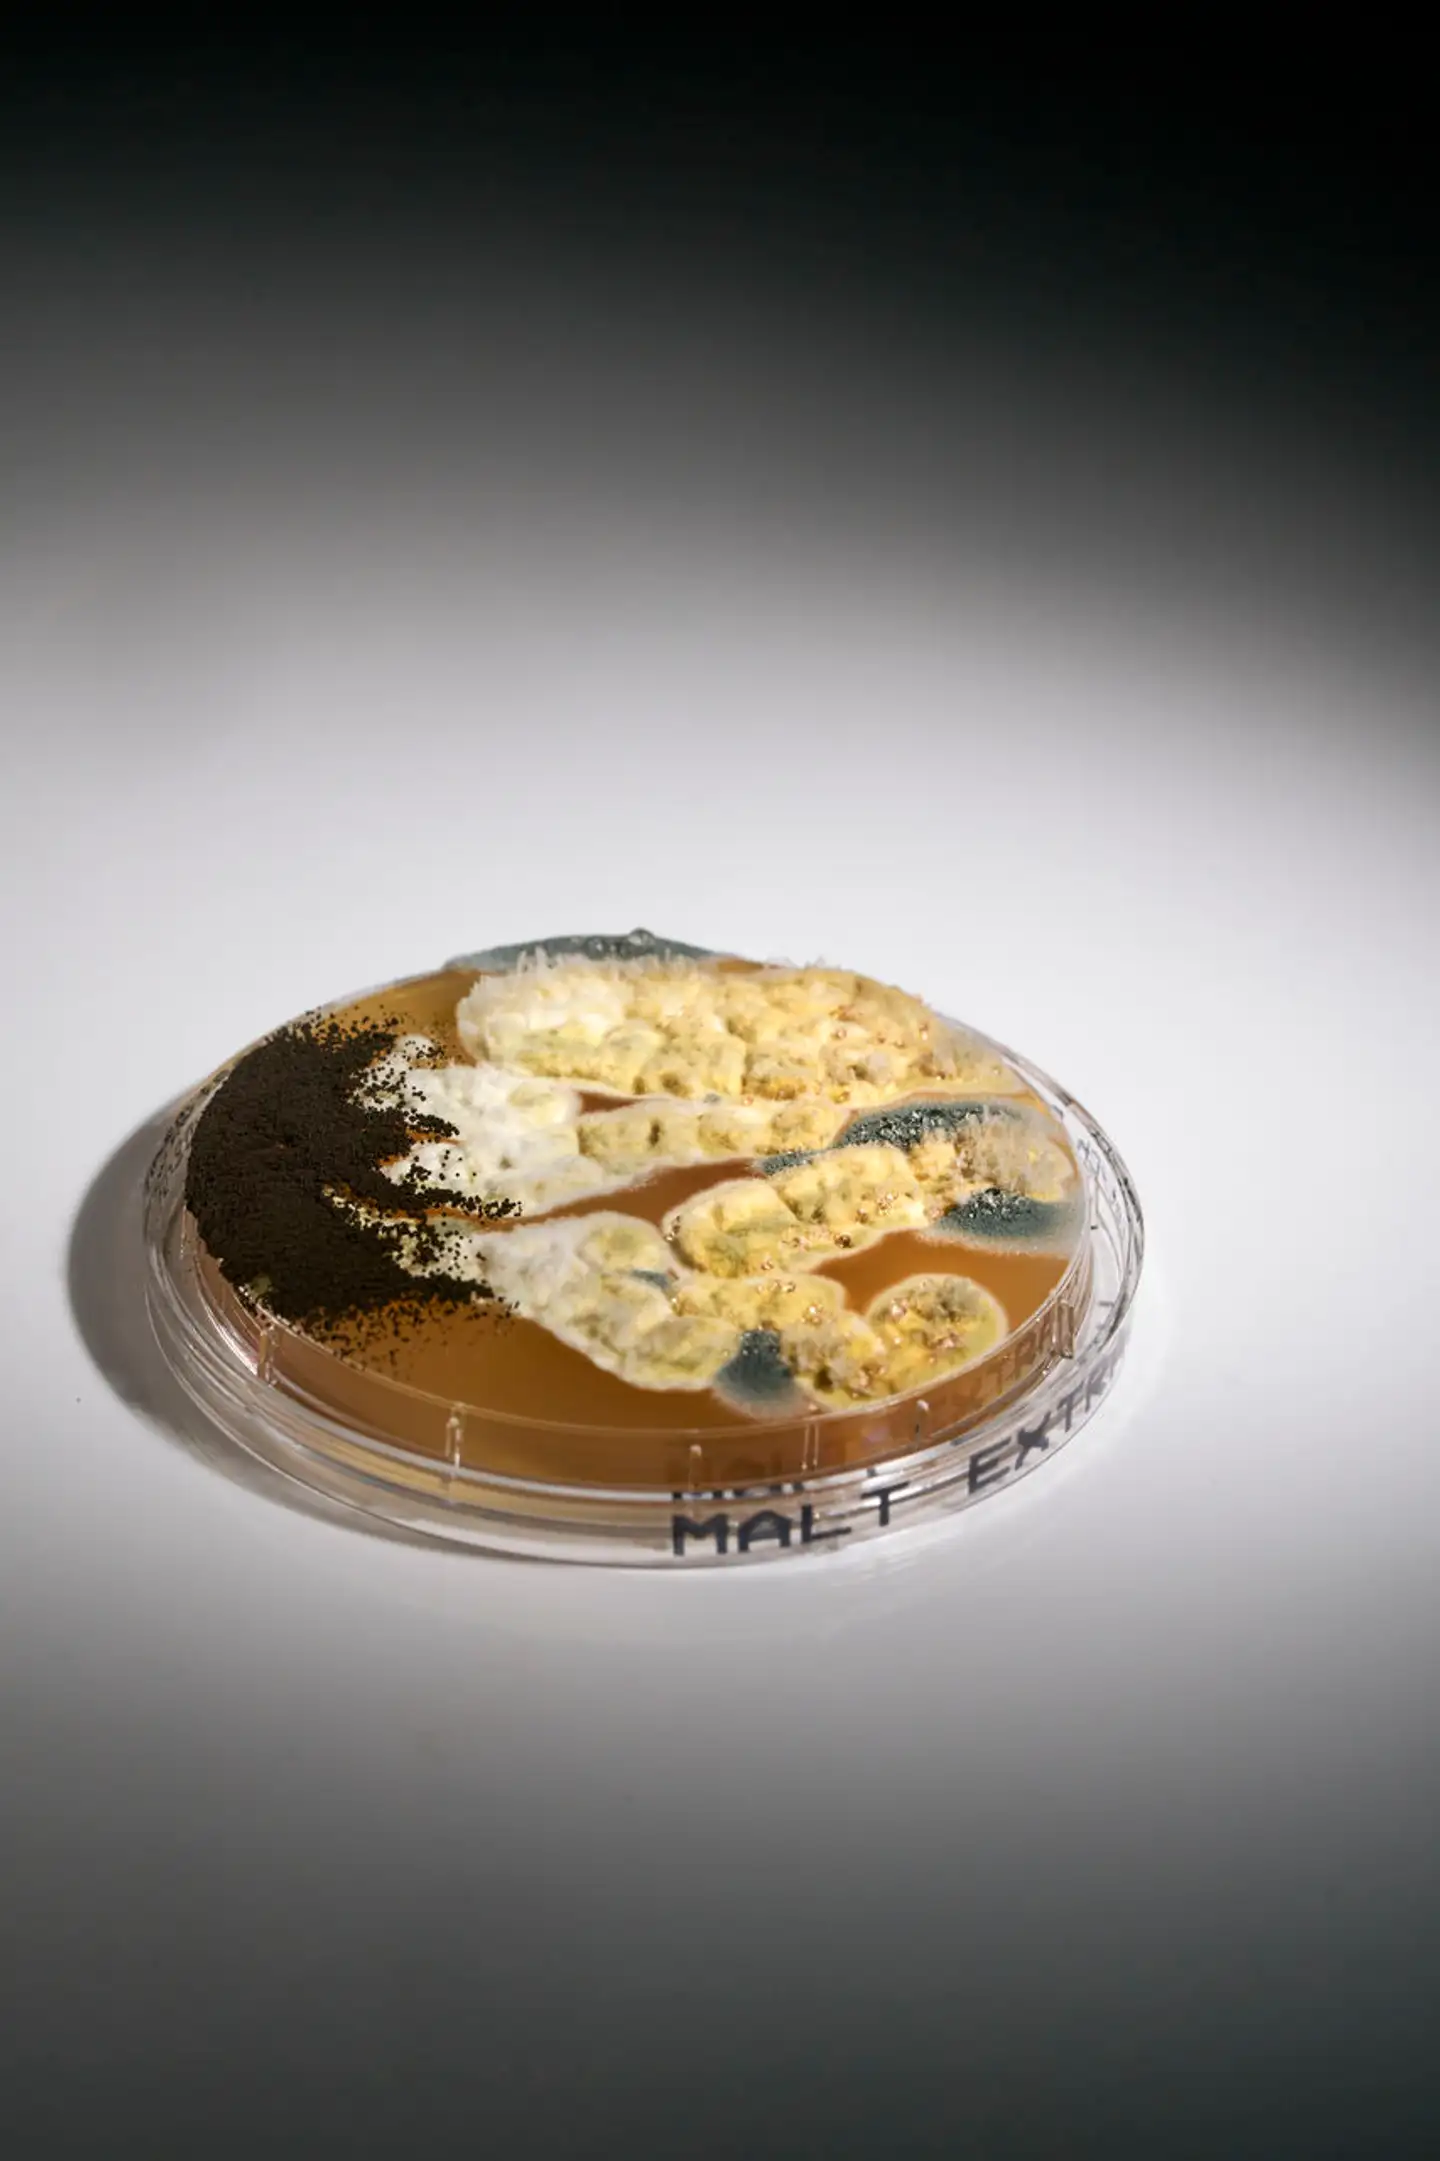

Det er Danmarks førende hospital, men der, hvor de allersvageste patienter ligger, truer skjulte skimmelsvampe
Mug i væggene, sygeligt udseende sorte pletter i badeværelsesfugerne og skimmelsvamp, der lurer i ventilationsskakterne. Siden 2018 har Rigshospitalet fundet giftige svampe mere end hundrede gange. »Det er naturligvis et særligt problem, hvis man finder det på de stuer og blandt de patienter, der er mest sårbare. Det må ikke ske,« siger lungespecialist.
Grunden under Rigshospitalet er gammel mose. Her lå blegedammene engang, og her gik blegemændene og fugtede deres store lærreder i det lave vand for derefter at lægge dem til blegning.
Det er ikke kun noget, der fortælles i introen til den populære tv-serie, Riget.
Fugt og vand har skabt et problem på Rigshospitalet, som kan blive fatalt for patienterne.
For Rigshospitalet har de seneste fem år haft massive problemer med skimmelsvampe.
Alene de seneste fem år er der registreret mindst 110 tilfælde af skimmelsvamp på Rigshospitalet, viser en gennemgang, som Berlingske har lavet på baggrund af data fra Region Hovedstaden.
To ud af tre gange bliver skimmelsvampene fundet på afdelinger for patienter, der ifølge Sundhedsstyrelsen ikke må komme i nærheden af skimmelsvampe. Det skyldes, at deres immunforsvar er så svækket, at de risikerer at få infektioner af svampene.
»Det er naturligvis et særligt problem, hvis man finder det på de stuer og blandt de patienter, der er mest sårbare. Det må ikke ske,« siger formand for Lungeforeningen, speciallæge Torben Mogensen.
Også Niels Høiby, der selv arbejder som overlæge på Rigshospitalet og er professor i klinisk mikrobiologi, betegner de talrige tilfælde af skimmelsvamp som et problem. Han understreger, at man i flere år har kendt til udfordringerne med skimmelsvampe på Rigshospitalet:
»Svampene opstår, når man har et ventilationssystem, som giver kondens. For når der er fugt, risikerer man jo at få skimmelsvamp,« siger lægen, som også har siddet i regionsrådet for Liberal Alliance fra 2013-2017.
Lørdag afdækkede Berlingske, hvordan syv kræftsyge børn er blevet syge med infektioner af skimmelsvampe, fordi de ikke har fået en god nok forebyggende behandling.
Nu kan Berlingske fortælle, at fagfolk bevæbnet med petriskåle og vatpinde har fundet skimmelsvampe, der kan være decideret livsfarlige for kræftpatienter og organtransplanterede flere steder på hospitalet. Også på både flere kræftafdelinger og på afdelinger for organtransplanterede børn.
Det er fundet på afdelinger for patienter med leukæmi, kræftsyge børn, nyfødte og for børn, som har fået en transplantation.
De er nemlig alle indlagt på Rigshospitalets sydkompleks. Og netop den bygning er særligt hårdt ramt af skimmelsvamp. Her er der fundet skimmelsvamp 66 gange siden 2018. Og nogle gange tager det måneder, før hospitalet får bugt med de sorte svampe.
»Det ligner et fuldkommen træls forløb for dem, der skal være i de her bygninger. Både de ansatte og patienterne. Og de her patienter er jo særligt sårbare, så det er ikke en god bygning at have de patienter i,« siger Torben Sigsgaard, der er professor på Institut for Folkesundhed på Aarhus Universitet.
Problemet kan være større, end det Berlingske kan omtale her. For de data, som Berlingske har fået udleveret, dækker kun over steder, hvor Rigshospitalet har fået biologer fra Teknologisk Institut eller Hussvamp Laboratoriet til at tage prøver.
Ifølge Regionens Center for Ejendomme kan der altså godt fjernes skimmelsvampe af for eksempel eksterne håndværkere, uden at det bliver registreret.
Men her er nogle af de vigtigste fund, Berlingske har gjort i rapporter fra Hussvamp Laboratoriet og de data, Region Hovedstaden har udleveret:
Fire sengestuer har været inficeret på afdelingen for organtransplanterede børn.
Der er fundet skimmelsvampe på fem sengestuer, i skoleklassen og på legestuen på afdelingen for kræftramte børn.
Hele afdelingen, hvor for tidligt fødte børn ligger, har døjet med skimmelsvampe efter en stor vandskade i 2021.
I 2023 har der især været mange fund af skimmelsvampe på den afdeling, hvor voksne leukæmi-patienter er indlagt.
De svampe, der er fundet på Rigshospitalet, som forskere er mest bekymrede for, er Aspergillus fumigatus, Stachybotrys chartarum og Aspergillus flavus. Rigshospitalet har haft et udbrud af infektioner med Aspergillus flavus, som ramte syv børn. Det kommer vi tilbage til.
I en e-mail til Berlingske skriver Rigshospitalets presseenhed, at de anerkender, at patienter kan blive inficeret af svampene, og at en infektion kan være fatal for immunsvækkede patienter.
»Der kan for et mindretal af særligt immunsvækkede være en risiko for skimmelsvampeinfektion, såfremt man opholder sig i et miljø eller et lokale med en høj koncentration af svampesporer,« skriver Rigshospitalets pressetjeneste til Berlingske.
40-60 procent kan dø
I de nationale retningslinjer for hygiejne på hospitaler opfordrer Statens Serum Institut til, at man ikke har potteplanter på patientstuer eller de steder, hvor patienter bliver behandlet eller undersøgt, da der er for stor en risiko for, at der kan sprede sig skimmelsvampesporer fra planterne.
Hvis der bliver fundet skimmelsvamp i et klasselokale, skal man stoppe med at bruge lokalerne, skriver Sundhedsstyrelsen i en pjece om helbredsproblemer ved skimmelsvamp.
Det skyldes, at man skal være ekstra forsigtig, når det er børn, der opholder sig i rum med skimmelsvamp.
»Uanset hvad man kommer frem til om sammenhænge mellem symptomer hos den enkelte patient og fugt eller skimmelsvamp i bygninger, skal der altid rådes til, at fugtskaderne udbedres,« skriver Sundhedsstyrelsen.

For når svampen først er flyttet ind i en patient med svækket immunforsvar på grund af kræftbehandling eller transplantationer, viser forskning fra Rigshospitalet, at patienten kun har 40-60 procents chance for at overleve:
»Det er en sygdom, som er behæftet med en betydelig dødelighed. Almindeligvis mellem 40 og 60 procent, men hvis svampen er resistent, så stiger dødeligheden helt op til 90 procent,« sagde professor Maiken Cavling Arendrup allerede i 2018 til DR.
Gemt i ventilationen
Der er skimmelsvampe omkring os hele tiden.
De lever i luften, i naturen og i væggene de fleste steder.
Og vi lever fint med dem, så længe de ikke er i vækst.
Men det har de været flere steder på Rigshospitalet.
Siden 2018 har Region Hovedstaden og Rigshospitalet fået udarbejdet flere rapporter af ingeniører, der viser, at hospitalet har problemer med skimmelsvamp i vækst på afdelingerne.
Efter at syv kræftsyge børn i årene 2017-2019 fik en infektion med den type skimmelsvamp, der hedder Aspergillus flavus, foretog hospitalet en række målinger af luften på børneafdelingen.
Målingerne viste, at der var skimmelsvamp i luften mange steder på afdelingen.
Det bekræftes af en intern korrespondance fra Rigshospitalet, som Berlingske har fået aktindsigt i.
»Der er taget prøver af luften i Afdeling for Børn og Unge. Prøverne viste vækst af skimmelsvamp fra luften i flere rum samt i skakter med rør på afdelingen,« står der i korrespondancen.

Men der skal slet ikke være skimmelsvamp på afdelinger, hvor børn og unge med kræft bliver behandlet, siger tidligere formand for Lungeforeningen, professor og overlæge Ole Hilberg.
»Der er tale om meget immunsvækkede patienter på sådan en afdeling, og for dem kan en svampeinfektion være fatal.«
Det er ikke alle svampe, der kan give mennesker infektioner. Men det kan blandt andet flere skimmelsvampe af typen aspergillus. Dem har man fundet flere steder på hospitalet.
Blandt andet har man fundet forskellige aspergillussvampe på barselsafsnittet. Her har man også fundet Stachybotrys chartarum, der populært også kaldes Black Killer Fungus. Det viser de rapporter, som Berlingske har fået indsigt i.
I USA er Stachybotrys chartarum tidligere blevet kædet sammen med lungeblødninger blandt spædbørn.
Arten er ifølge rapporter fra Hussvamp Laboratoriet også fundet på en kræftafdeling for voksne, og den er så giftig, at eksperter, Berlingske har talt med, og som hver dag arbejder med skimmelsvamp, ikke vil være i samme rum som den.
Ikke uden massiv beskyttelse i hvert fald.
Tidlig advarsel
De seneste fem år er det primært den private virksomhed Hussvamp Laboratoriet, der har podet vægge og gulve på Rigshospitalet for skimmelsvamp med kontaktskåle og vatpinde.
For hver positiv prøve, de laver på Rigshospitalet, udarbejdes en rapport, der beskriver, hvilke typer af svamp der er fundet, og hvordan de skal bekæmpes.
Berlingske har trods gentagne anmodninger om aktindsigt kun fået adgang til 26 af de 184 rapporter, der er lavet i årene 2018-2023.
Men mange af de rapporter, vi har læst, fortæller en dyster historie om, at flere af de skimmelsvampe, der er fundet i væggene på hospitalet, kan give patienterne fatale infektioner, hvis de har nedsat immunforsvar.
Her kan vi blandt andet se, at der er fundet skimmelsvampe i vækst på den afdeling, hvor børn, som får transplanteret knoglemarv og stamceller, ligger.

»Der må altså ikke være skimmelvækst der, hvor hospitalet indlægger transplanterede patienter, som har et nedsat immunforsvar. For så bliver de eksponeret for infektioner. Især fra aspergillusarterne.«
Sådan siger også Suzanne Gravesen. Hun er pensioneret seniorforsker på Statens Byggeforskningsinstitut og har viet sit arbejdsliv til at undersøge skimmelsvampe.
»Aspergillussvampene, som I jo viser, er blevet fundet på Rigshospitalet, kan være et problem,« siger Suzanne Gravesen og uddyber:
»Der er ikke så mange svampe, der kan give infektioner. Og sunde og raske mennesker slår svampen ned, før den bliver et problem. Men patienter med nedsat immunforsvar er i risiko for at få infektioner af aspergillussvampe. Og netop de patientgrupper er der mange af i Sydkomplekset.«
Allerede i 1990erne undersøgte Suzanne Gravesen en afdeling på hospitalet for skimmelsvamp, fortæller hun:
»Dengang fandt jeg en del skimmel i fugerne på badeværelserne. Så man må sige, at de selv har været opmærksomme på det allerede da.«
Rigshospitalet anerkender problemet
Berlingske har gentagne gange spurgt efter et interview med de personer på Rigshospitalet, der forsker i skimmelsvampe.
Det er blevet afvist af hospitalets presseafdeling, der i stedet har bedt om at få spørgsmål på skrift.
Hospitalets kommunikationsafdeling oplyser i et skriftligt svar, at særligt immunsvækkede patienter kan risikere at få skimmelsvampeinfektioner, såfremt de opholder sig et sted, hvor der er mange svampesporer.
»Helt generelt skal det siges, at Rigshospitalet og Center for Ejendomme, der har ansvaret for bygningsmassen i Region Hovedstaden, er meget opmærksomme på, om der opstår skimmelsvamp i bygningsmassen,« skriver Rigshospitalets kommunikationsenhed i en mail til Berlingske og fortsætter:
»De gamle bygninger er visse steder meget slidte og trænger til renovering, og det kalder naturligt på særlig årvågenhed.«
De skriver, at svampeinfektioner sjældent skyldes, at der er en høj koncentration af skimmelsvamp, men at nogle patienter har så svækket et immunforsvar, at de kan blive syge bare af at være i deres eget hjem eller i naturen.
Fugtigt sygehus
Skimmelsvamp er som en plante. Hvis der er vand, kan den vokse.
»I sidste ende handler Rigshospitalets problemer med skimmelsvampe om, at de har et problem med fugt,« siger Suzanne Gravesen.

Og det gentager Torben Sigsgaard fra Aarhus Universitet, da han har gennemgået de skimmelprøver, Berlingske har fået aktindsigt i.
»De her data peger mest af alt på en bygning, der har problemer med vandskader. Det må være højst irriterende. Men om det er farligt eller ej, er svært at sige,« siger han og tilføjer:
»Men de har dyrket nogle af de svampe, der er vokset i hospitalets vægge, for at kunne artsbestemme dem, og det, at de finder aspergillussporer, giver anledning til panderynken. For det skal helst ikke være fra bygningen selv, de kommer.«
Men det gør det. Og det er der en god grund til.

Problemet skyldes ifølge Rigshospitalets egen driftsledelse bygningens vandrør. I Sydkompleksets 50 år lange levetid er de aldrig blevet skiftet.
Det er dog lidt mere komplekst end det, mener Michael Langgaard, der er vicedirektør hos Center for Ejendomme i Region Hovedstaden:
»Vi har en bygningsmasse, som er så gammel, at den begynder at være slidt. Derfor ser vi tæringer af både vandrør og afløb, som kan give opfugten af væggene,« siger han og tilføjer flere grunde til, at skimmelsvampen er opstået på hospitalet:
Det kan både skyldes dårlige materialer, som man brugte, da man opførte hospitalet i 1960erne og 1970erne. Det kan også skyldes dårligt håndværk. Det kan skyldes, at selve ydermurene er nedslidte.
Men det lyder til, at vandrørene er en af årsagerne til, at der er opstået skimmelsvamp flere gange på hospitalerne. Har I skiftet dem, efter det stod klart?
»Nej, det har vi ikke. Vi kender tilstanden på installationerne, og vi har den her renoveringsplan. Man kan jo ikke bare lukke et hospital og renovere. Der er stadig patienter, der skal behandles.«

Problemet for Region Hovedstaden er, at man ikke kan komme videre med sin renoveringsplan. Regionen er kort sagt løbet tør for penge til at renovere sine bygninger på grund af inflation og stigende materialepriser, siger formanden for regionens sundhedsudvalg, Christoffer Buster Reinhardt (K).
»Jeg synes, det her er forfærdeligt. Det må jeg nok sige. Og det er jo hospitalets ansvar at sørge for, at der er sikkert for patienterne. For nogle patientgrupper er det mere alvorligt med skimmelsvamp, end det er for alle os andre, der ikke har nedsat immunforsvar. Derfor forventer jeg også, at Rigshospitalet får rettet op på det her,« siger han.
Berlingske har i løbet af de seneste tre måneder haft en meget lang korrespondance med spørgsmål og svar til og fra Rigshospitalet og Region Hovedstaden. Derfor er vi nødt til at prioritere og samskrive flere af svarene i vores artikler. Men skulle du ønske at læse alle de svar, hvor Rigshospitalets presseafdeling har skrevet svarene på en måde, så det må forventes, at de er til offentliggørelse, finder du dem her.
Del: